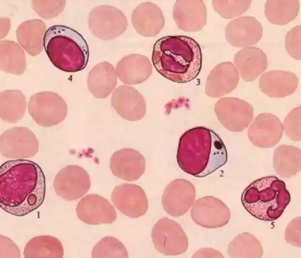
image.png

人體干細(xì)胞價(jià)格差異大,為何會(huì)有這樣的區(qū)別
2024-11-22 14:56:04 來源: 小編 咨詢醫(yī)生
人體干細(xì)胞作為一種重要的生物資源,在醫(yī)學(xué)研究和臨床治療中具有廣泛的應(yīng)用前景。然而,在市場上,人體干細(xì)胞的價(jià)格卻存在很大的差異。本文將從以下幾個(gè)方面探討人體干細(xì)胞價(jià)格差異的原因,以幫助讀者了解這一現(xiàn)象背后的奧秘。
一、干細(xì)胞來源不同導(dǎo)致價(jià)格差異
1.來源種類:人體干細(xì)胞有多種來源,如胚胎干細(xì)胞、成體干細(xì)胞、誘導(dǎo)多功能干細(xì)胞等。不同來源的干細(xì)胞在功能、分化能力等方面存在差異,導(dǎo)致價(jià)格也有所不同。
2.采集難度:胚胎干細(xì)胞的采集需要破壞胚胎,存在倫理問題,且采集難度較大。而成體干細(xì)胞主要來源于骨髓、脂肪、血液等,采集相對(duì)容易。因此,胚胎干細(xì)胞的價(jià)格普遍高于成體干細(xì)胞。
二、制備工藝和純度影響價(jià)格
1.制備工藝:制備干細(xì)胞需要復(fù)雜的生物技術(shù)工藝,包括細(xì)胞的分離、培養(yǎng)、擴(kuò)增等。不同制備工藝的成本差異,會(huì)導(dǎo)致干細(xì)胞價(jià)格的高低。
2.純度:干細(xì)胞純度越高,其分化能力和應(yīng)用前景越好。高純度干細(xì)胞在制備過程中需要更多的技術(shù)和設(shè)備投入,因此價(jià)格相對(duì)較高。
三、市場需求與供應(yīng)關(guān)系
1.市場需求:隨著干細(xì)胞技術(shù)在醫(yī)學(xué)領(lǐng)域的廣泛應(yīng)用,市場需求逐漸增加。在供不應(yīng)求的情況下,干細(xì)胞價(jià)格自然上漲。
2.供應(yīng)渠道:不同供應(yīng)商的干細(xì)胞質(zhì)量、服務(wù)等因素也會(huì)影響價(jià)格。正規(guī)渠道的干細(xì)胞價(jià)格相對(duì)較高,但質(zhì)量有保障。
四、**法規(guī)和倫理因素
1.**法規(guī):國家對(duì)干細(xì)胞研究、應(yīng)用有嚴(yán)格的法律法規(guī),如《人體器官移植條例》等。合規(guī)的干細(xì)胞產(chǎn)品價(jià)格相對(duì)較高。
2.倫理因素:胚胎干細(xì)胞的研究涉及倫理問題,部分國家和地區(qū)對(duì)其進(jìn)行了限制。這使得胚胎干細(xì)胞的價(jià)格受到一定影響。
五、結(jié)論
人體干細(xì)胞價(jià)格差異大的原因主要包括干細(xì)胞來源、制備工藝、市場需求、**法規(guī)和倫理因素等。了解這些原因,有助于我們正確認(rèn)識(shí)干細(xì)胞市場的現(xiàn)狀,并為未來干細(xì)胞技術(shù)的發(fā)展提供參考。在選購干細(xì)胞產(chǎn)品時(shí),應(yīng)充分考慮價(jià)格與質(zhì)量的關(guān)系,選擇正規(guī)渠道購買,以確保安全有效。
- 2024-08-28干細(xì)胞手術(shù)治療肺癌效果及費(fèi)用介紹
- 2024-09-27骨科干細(xì)胞注射費(fèi)用多少?效果持續(xù)多久?
- 2024-10-22杭州牙髓干細(xì)胞價(jià)格如何?值得投資嗎?
- 2024-10-10植物干細(xì)胞再生療法價(jià)格多少?效果對(duì)比分析
- 2024-11-13醫(yī)院推薦做干細(xì)胞移植多少錢一次
- 2024-11-04甘肅培養(yǎng)干細(xì)胞價(jià)格是多少?價(jià)格影響因素有哪些?
- 2024-09-27貝拉細(xì)胞醫(yī)院怎么樣
- 2024-10-11干細(xì)胞治療癲癇需要多久見效?真的有效果嗎?
- 2024-09-11干細(xì)胞再生技術(shù)哪個(gè)國家最先進(jìn),綜合排名前五名
- 2024-08-13干細(xì)胞技術(shù)與美容,干細(xì)胞美容技術(shù)成熟嗎
- 2024-09-12蘋果干細(xì)胞有副作用嗎,附功效和注意事項(xiàng)
- 2024-09-20打干細(xì)胞抗衰老有副作用嗎
- 2024-09-07干細(xì)胞瘦小腿效果好嗎,干細(xì)胞減肥原理分析
- 2024-10-10植物干細(xì)胞再生療法價(jià)格多少?效果對(duì)比分析
- 2024-08-07干細(xì)胞治療的最新消息,干細(xì)胞治療的副作用有哪些
- 2024-09-18自體干細(xì)胞移植的危害有多大,技術(shù)成熟嗎
- 2024-09-24干細(xì)胞免疫療法臨床意義和價(jià)值
- 2024-09-26廣州干細(xì)胞儲(chǔ)存費(fèi)用,附上機(jī)構(gòu)價(jià)格明細(xì)
